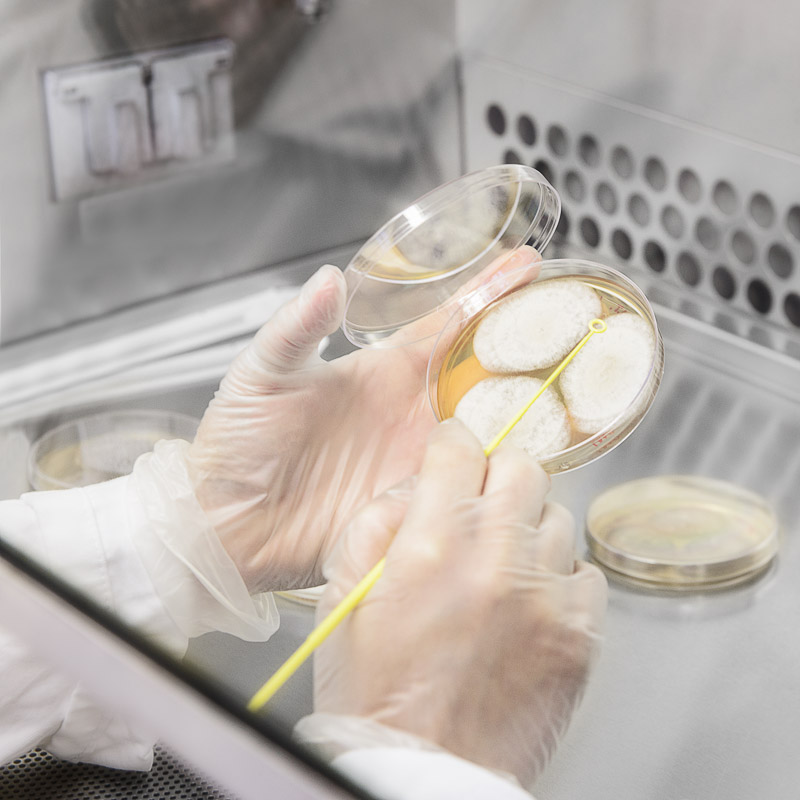

Suivez-moi également sur :
Recevez les avis de nouveaux articles
Au fil du temps
Mois antérieurs
Parcourez mon blogue par thème avec ce nuage de mots clé
Acadia National Park automne Baie Saint-Paul bateaux bernaches bijoux Boeufs highlands chats Chevaux chiens Claudel faune fleurs Fleurs. Macrophotographie fleuve Saint-Laurent flore Grand défi Pierre Lavoie hiver lever de soleil Macrophotographie Maine mars Montréal navigation Parc National d'Acadia Paris paysage Paysage urbain pedro Photo animalière photo culinaire photographie culinaire photographie rapprochée photoreportage portrait printemps Québec studio Voyage zoothérapie États-Unis Île-d'Orléans érables érablière été
 1cmH.png)
10

Recevez des avis de publication